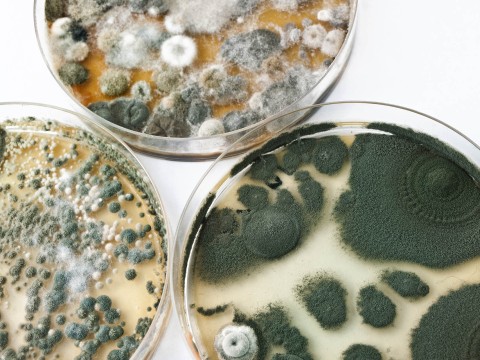
mold

重要
mold
🇬🇧/məʊld/ 🇺🇸/moʊld/📚 6168托福the distinctive form in which a thing is made; "pottery of this cast was found throughout the region"
noun [专属名词]模具;铸模;模制品;类型,个性,风格;框架;体型,模样;霉,霉菌;耕作土壤;松软沃土
He understood what the mold did.
他明白了霉菌的作用。
verb [vt. 及物动词]浇铸,塑造;用模子制作;对……影响重大;将……塑造成;使)紧贴于,吻合;轮廓相符;使发霉
What color is mold?
模具是什么颜色?
noun [专属名词](Mold)(美、英、奥地利)莫尔德(人名)
Mold is usually green, white, black or gray.
霉菌通常为绿色、白色、黑色或灰色。
单词造句: